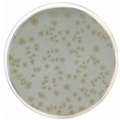

Alergen určený na 4 stimulace standardizovaný a validovaný pro použití se soupravami CAST® ELISA a FLOW CAST®.

CE IVD certifikovaný diagnostický kit pro detekci mutace -1639G>A promotoru genu lidského Vitamín K Epoxid Reduktázového komplexu 1 (VKORC1). Tento polymorfismus je nejrelevantnější taq-SNP spojený s interpacientskou variabilitou dávkování orálních antikoagulancií, jako je warfarin, phenprocoumon nebo acenocoumarol.

Diatabs™ identifikační tablety určené ke kvalitativní detekci mikrobiálních charakteristik při identifikaci mikroorganismů.

VRE agar (BHI s obsahem vankomycinu) se používá k orientační detekci vankomycinové rezistence např. u kmenů Enterococcus sp.; (lze využít i k detekci MRSA s mírně modifikovaným postupem testování).

Promývací roztok

Selektivní krevní agar pro anaerobní bakterie. Vhodný pro zpracování klinických vzorků, u kterých se dá očekávat smíšená flóra. Vzhledem k přítomnosti neomycinu dochází k inhibici růstu fakultativně anaerobních Gram-negativních bakterií, zejména čeledi Enterobacteriaceae. (Gram-negativní striktně anaerobní mikroorganizmy na půdě rostou, např. Bacteroides fragilis).

WCHGN je selektivní médium určené pro kultivaci a izolaci Gram negativních anaerobních mikroorganizmů z klinického materiálu.

Pro růst a testování citlivosti anaerobních bakterií z klinických vzorků. Tento produkt je dodáván v dehydratované formě a je určen pro přípravu hotových kultivačních médií.

- kultivace a izolace anaerobních mikroorganizmů z klinického materiálu
- stanovení citlivosti anaerobních mikroorganizmů agarovou diluční metodou
Pro testování citlivosti a pro izolaci a kultivaci anaerobních bakterií obecně z klinických vzorků. Tento produkt je dodáván v dehydratované formě a je určen pro přípravu hotových kultivačních médií.

Cílený a komplexní NGS panel pro detekci de novo fúzí genů spojených s akutní lymfoblastickou leukémií.

Cílený a komplexní NGS panel pro sekvenování celého lidského genomu. Unikátní technologie využívající molekulární barkódování.

Cílený a komplexní NGS panel pro detekci de novo fúzí genů spojených s lymfomy.

Cílený a komplexní NGS panel pro detekci de novo fúzí genů spojených s myeloidními nádory.

Cílený a komplexní NGS panel pro detekci de novo fúzí genů spojených se sarkomy.

Cílený a komplexní NGS panel pro detekci SNV, CNV a indels v genech spojených s nádory prsu.

Cílený a komplexní NGS panel pro detekci SNV, CNV a indels v genech spojených se solidními nádory.

Cílený a komplexní NGS panel pro detekci SNV, CNV a indels v genech spojených s nádory plic.